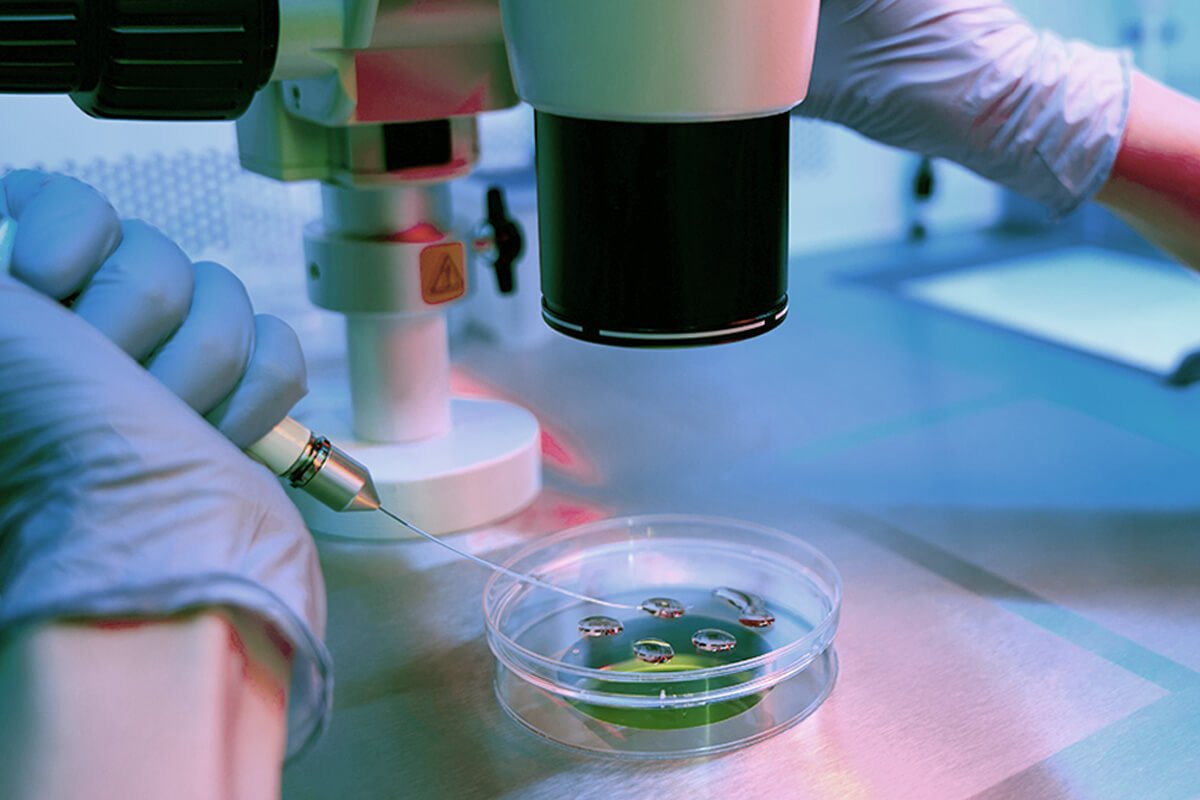

Vitrificação De Embrioes Em Marilia
Congelamento de Óvulos é uma técnica avançada de preservação da fertilidade que permite às mulheres adiarem a maternidade sem comprometer suas chances de concepção futura. Nesse procedimento, os óvulos são coletados e armazenados em baixas temperaturas para uso posterior.
Quando Congelar Óvulos?
Se você deseja postergar a gravidez por motivos pessoais ou médicos, Congelar Óvulos
pode ser uma opção adequada. É especialmente indicado em casos como:
- Tratamentos oncológicos: mulheres prestes a iniciar quimioterapia ou radioterapia que podem afetar a fertilidade.
- Histórico familiar de menopausa precoce: para preservar a possibilidade de gravidez futura.
- Adiamento da maternidade: por razões profissionais, educacionais ou pessoais.
- Condições médicas: como endometriose ou doenças autoimunes que podem impactar a reserva ovariana.
Congelar Óvulos: como funciona?
- Estimulação ovariana: uso de medicamentos hormonais para estimular os ovários a produzirem múltiplos óvulos.
- Monitoramento: acompanhamento do desenvolvimento folicular por ultrassonografias e exames hormonais.
- Coleta dos óvulos: procedimento minimamente invasivo, realizado sob sedação, para aspirar os óvulos maduros.
- Vitrificação: congelamento ultrarrápido dos óvulos, garantindo maior taxa de sobrevivência após o descongelamento.
- Armazenamento: os óvulos são mantidos em tanques de nitrogênio líquido até o momento desejado para uso.
Qual o tempo de tratamento?
O processo completo de Congelamento de Óvulos
, desde a estimulação ovariana até a coleta dos óvulos, geralmente dura entre 10 e 14 dias. Para pacientes de outras localidades, oferecemos suporte por telemedicina, permitindo que parte do acompanhamento seja realizada remotamente, reduzindo a necessidade de deslocamentos frequentes.
Taxas de sucesso do Congelamento de Óvulos
As taxas de sucesso do Congelamento de Óvulos
dependem principalmente da idade da mulher no momento do congelamento e da qualidade dos óvulos. Mulheres que congelam seus óvulos antes dos 35 anos tendem a ter maiores chances de sucesso em futuras tentativas de gravidez. Para uma avaliação personalizada, agende uma consulta com nossa especialista.
Valor do Congelamento de Óvulos?
O valor para congelar óvulos varia conforme as necessidades individuais, incluindo a quantidade de medicação necessária e possíveis técnicas adicionais. Após uma avaliação médica detalhada, forneceremos um orçamento adaptado ao seu caso.
Se você está buscando Vitrificação De Embrioes Em Marilia , a Dra. Ludmila Bercaire oferece duas modalidades de atendimento: presencial, na Begin Clinic, localizada no bairro Itaim Bibi, em São Paulo - SP, e remoto, por telemedicina, disponível para todo o Brasil e exterior. Conheça as opções abaixo:
Atendimento Presencial em São Paulo
Para pacientes que residem ou podem se deslocar até a capital paulista, a Dra. Ludmila Bercaire realiza todas as consultas de forma presencial e acompanha as etapas essenciais do tratamento de fertilização in vitro na Begin Clinic. A clínica conta com estrutura moderna e equipe especializada, garantindo um atendimento de excelência.
Tratamento à Distância para Vitrificação De Embrioes Em Marilia
Para pessoas que residem em outras cidades ou países, é possível realizar grande parte do tratamento de forma remota com o mesmo cuidado e qualidade de atendimento. A Dra. Ludmila Bercaire utiliza a telemedicina para oferecer consultas acessíveis e personalizadas, com suporte contínuo em todas as etapas. Confira como funciona:
Consulta Inicial Online
A primeira consulta é realizada de forma remota, permitindo que pacientes de qualquer localidade discutam seu histórico médico, expectativas e dúvidas com a Dra. Ludmila Bercaire. Esse momento é essencial para criar um plano de tratamento detalhado e adaptado às suas necessidades.
Protocolo de Tratamento à Distância
Após a consulta inicial, os exames e parte do tratamento podem ser realizados na cidade onde o paciente reside, em parceria com médicos e laboratórios locais. A Dra. Ludmila Bercaire coordena todo o processo, garantindo que cada etapa seja conduzida com segurança e precisão. Consultas de seguimento também são realizadas de forma remota, para avaliação de exames e discussão sobre o planejamento do tratamento. Viagens para São Paulo são necessárias apenas em momentos específicos do tratamento.
Tecnologia e Humanização
A Begin Clinic utiliza tecnologia de ponta e plataformas de telemedicina para oferecer tratamentos de reprodução assistida com excelência e comodidade. Além disso, o atendimento é humanizado, garantindo que todos os pacientes, independentemente de sua localização, sintam-se acolhidos e respeitados.
Se você busca Vitrificação De Embrioes Em Marilia , entre em contato com a nossa equipe para mais informações e agende sua consulta, presencial ou online.
Agende sua Consulta
Ginecologista Especialista em Vitrificação De Embrioes À Distância Para Pacientes Em Marilia
A Dra. Ludmila Bercaire é ginecologista, obstetra especialista em fertilidade. Possui mais de uma década de experiência em Reprodução Humana e Ginecologia e é Sócia Fundadora da Begin Clinic Medicina Reprodutiva. Formada pela Faculdade de Medicina UFRJ e com Mestrado pela Faculdade de Medicina da UNESP, hoje integra o corpo clínico dos melhores hospitais de São Paulo, como o Albert Einstein, e atua nos laboratórios de reprodução assistida mais modernos do país.
CRM: 145773-SP
RQE: 49731 (GINECOLOGIA E OBSTETRÍCIA)
RQE: 497311 (REPRODUÇÃO ASSISTIDA)
Currículo Lattes: http://lattes.cnpq.br/6671796676034947
Para agendar uma consulta com a Dra. Ludmila Bercaire, entre em contato através do nosso WhatsApp.
Agende sua Consulta